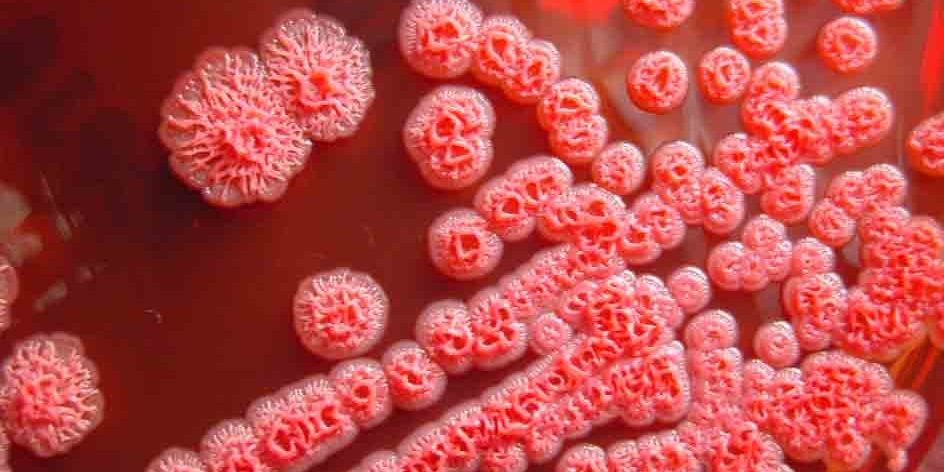

Возраст рано или поздно настигает всех, но у некоторых людей правильные гены могут сделать эту погоню в наши сумерки относительно неторопливой. Несколько лет назад итальянские исследователи обнаружили кое-что особенное в людях, которые доживают до 90 лет и старше: у них обычно есть версия гена, называемая BPIFB4, которая защищает от сердечно-сосудистых заболеваний и поддерживает сердце в хорошей форме в течение более длительного периода времени.
Внедрив мутантный ген старым мышам, ученые увидели, как этот вариант перематывает маркеры биологического старения сердца на более чем 10 человеческих лет. Было показано, что у мышей среднего возраста такая же терапия останавливает снижение сердечной функции.
Как быстро сердце и ближайшие к нему кровеносные сосуды обычно распадаются, зависит от множества факторов, в том числе от наличия вредных привычек. Согласно результатам исследования, мутации в генах, кодирующих белки, также играют ключевую роль.
Ассоциированный с долголетием вариант (LAV) гена BPIFB4, который рассматривали исследователи, уже связан с долголетием у людей и часто встречается у людей, которые живут дольше, чем обычно, в том числе у тех, кому за 90 и старше. Это открытие побудило исследователей более внимательно изучить физиологические эффекты варианта.
Помимо испытаний на мышах, команда добавила ген в клетки человеческого сердца в лабораторных условиях, чтобы увидеть, каковы будут результаты. Клетки были взяты у 24 пожилых пациентов с серьезными проблемами с сердцем, в том числе у тех, кто ранее перенес трансплантацию сердца.
Результаты показали, что LAV-BPIFB4 играет важную роль в поддержании клеток перицитов. Работа этих клеток включает в себя строительство новых кровеносных сосудов и поддержание их в хорошем состоянии, что, в свою очередь, позволяет дольше поддерживать нормальное функционирование сердца.
«Обнаружено, что клетки пожилых пациентов, в частности те, которые поддерживают строительство новых кровеносных сосудов, называемые перицитами, менее эффективны и стареют», — поясняет ведущий автор исследования Моника Каттанео из IRCCS Multimedica Group в Италии. «Добавив ген/белок долголетия в пробирку, мы наблюдали процесс омоложения сердца: сердечные клетки пожилых пациентов с сердечной недостаточностью возобновили нормальное функционирование, доказав свою эффективность в построении новых кровеносных сосудов».
В то время как долгожители естественным образом передают мутацию гена BPIFB4 своим детям, предполагается, что это может быть адаптировано в качестве терапии для людей, чьи родители не дожили до глубокой старости и которые испытывают проблемы с сердцем.
Уже было известно, что перенос гена BPIFB4 мышам останавливает атеросклероз, диабет и другие осложнения, и в будущем можно будет использовать клинические испытания, чтобы увидеть, проявляются ли такие же профилактические эффекты у людей.
Исследователи также изучают возможность применения в качестве лечения белка BPIFB4, а не гена BPIFB4, который его генерирует. Хотя возможны оба варианта, применение белков безопаснее и проще.
«Наши результаты подтверждают, что здоровый мутантный ген может обратить вспять снижение сердечной деятельности у пожилых людей. Теперь мы заинтересованы в том, чтобы определить, может ли также работать введение белка вместо гена», — подытожили исследователи.
материал med2.ru